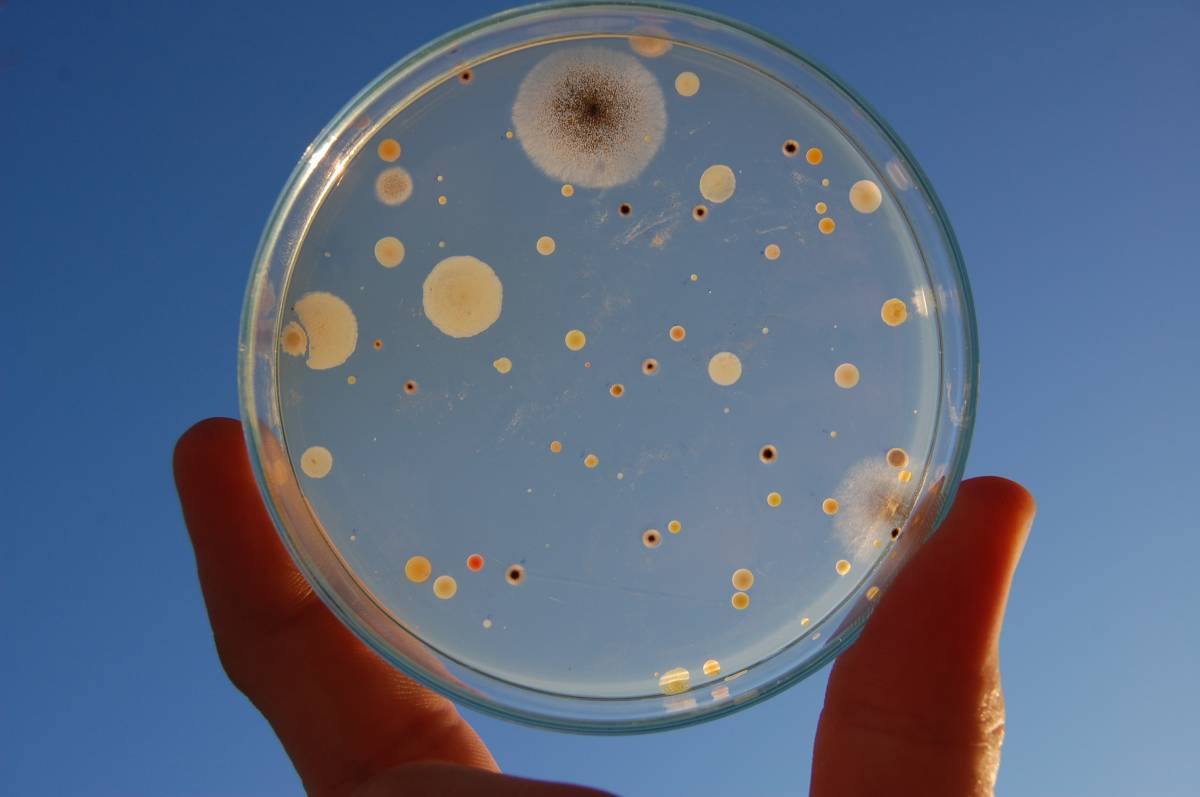

A Sapientia Erdélyi Magyar Tudományegyetem Csíkszeredai Karának környezetmérnöki szakán tanuló diákok szakmai munkájának fontos része a mikrobiológiai laborgyakorlatok, ahol kútvizek vagy légterek tisztaságát is vizsgálják.
2016. február 05., 12:442016. február 05., 12:44
2016. február 05., 19:402016. február 05., 19:40
A Sapientia EMTE Csíkszeredai Karának környezetmérnök szakos hallgatói számára a mikrobiológiai laborgyakorlatok egyik legizgalmasabb része, amikor minden diák steril edényekben otthonról hoz vízmintát (kútvíz, ásványvíz, csapvíz) és kielemzi mikrobiológiailag. A szabványos bakteriológiai vizsgálatok (pl. baktériumok összcsíraszámának, fekális enterokokkuszok jelenlétének kimutatása) során kiderül, hogy az adott vízminta megfelel vagy sem az ivóvizekre vonatkozó előírásoknak.
Baktériumok a kútvizekben
Dr. Máthé István a környezeti mikrobiológiai laborgyakorlatokat vezeti. Az oktató szerint nem ritka, hogy a szűkebb vagy tágabb vidékünkről származó egyes vízmintákban (főként kútvizekben) a megengedettnél magasabb a baktériumok száma (amelyek elsősorban a talajból származnak), de fekális eredetű szennyezések is kimutathatók, főként hóolvadáskor vagy nagyobb esőzések után. Kedvezőtlen eredmények esetén javasolják a diákoknak, hogy fertőtlenítsék a kútjaikat klór alapú fertőtlenítőszerrel, majd a hatásidő lejárta után jól szivattyúzzák ki a vizet a kútból.
Csíkszereda levegőjéről
Az ivóvizek mellett épületek belső légterének, illetve Csíkszereda levegőjének mikrobiális terheltségét is vizsgálják. Ilyenkor a laborokban, az egyetem előterében, bentlakási vagy otthoni szobákban, a város különböző pontjain vesznek mintákat a diákok. Két nap múlva, miután a mikrobák elszaporodtak a táptalajokon, meg lehet állapítani, hogy az adott mintavételi helyen egy köbméter levegőben mennyi volt a baktériumok illetve penészgombák száma. Máthé István elmondta, hogy a városi levegő mikrobiális terheltségét sok minden befolyásolhatja – széljárás, csapadék, hőmérséklet, járműforgalom, évszakok stb. –, mélyreható következtetések levonására azonban sok vizsgálatra lenne szükség.
Mintavétel több helyszínen
Ugyanakkor a város különböző pontjain ugyanabban az időpontban vett levegőminták vizsgálatának eredményei összevethetők egymással. „Így például 2015. február 20-21-én több környezetmérnök hallgató segítségével egy nagyobb vizsgálatot végeztünk, amikor hat csíkszeredai helyszínen (a központi piac, a Szabadság tér, a központi park, az ifjúsági park, a BCR Bank-, illetve a megyei törvényszék melletti körforgalom) vettünk mintákat: 16 órakor a délutáni csúcsforgalomban, illetve éjjel 1 órakor. A vizsgálati időszakban nem hullott csapadék, és számottevő szélmozgás sem volt.”
Az eredmény
Az eredmények alapján megállapítható, hogy nappal a baktériumok csíraszáma a legalacsonyabb volt a két parkban és a központi piacnál (500-600 baktérium/m3 levegő). A főtéren 1000, míg a két körforgalomnál 3000 körül volt a baktériumok száma légköbméterenként. Éjszakára jelentősen csökken a csíraszám a legtöbb vizsgált helyszínen. Amint az várható volt, a legnagyobb csökkenés a körforgalmaknál volt tapasztalható, a BCR banknál levő körforgalomnál 46%-ban, míg a törvényszékinél 77%-al csökkent a baktériumok száma, ami nyilvánvalóan összefügg a csökkent autósforgalommal és a kevesebb szállóporral. Az egyetemi tanár szerint ugyanakkor elmondható, hogy Csíkszereda levegőjéből kimutatott baktériumszámok normál értékeknek számítanak téli időszakban, városi kültéri területeken.
Vegyszerek hatásának vizsgálata
További nagy vizsgálati témakör laborgyakorlatokon a háztartásban használt vegyszerek (pl. fertőtlenítőszerek, tisztító- és mosogatószerek, kozmetikai termékek) és különböző gyógyszerek antimikrobiális hatásának a tanulmányozása. Máthé István szerint sok esetben nagyon látványos, ahogyan az adott vegyszer vagy gyógyszer gátolja a környezetébe oltott különböző laboratóriumi mikrobatenyészetek szaporodását, így ún. gátlási zónák alakulnak ki. Minél nagyobb ennek a zónának az átmérője, annál erőteljesebben hat az adott antibiotikum az illető mikroorganizmusra.
„A fentiek és a többi mikrobiológiai laborgyakorlatok – például különböző (bőr)felületeken levő mikroorganizmusok tanulmányozásának – elsődleges célja, hogy a diákok hétköznapi, széles érdeklődésre is számot tartó gyakorlatias vizsgálatokat végezzenek el és értékeljenek ki. A megtanult alap mikrobiális technikák azok gyakorlatilag megegyeznek a világ bármely részén ipari-, vízügyi-, orvosi-, vagy kutatói laborokban használt technikákkal” – hangsúlyozta Máthé István.
Halálos baleset történt pénteken este Csíkszereda közelében: egy 17 éves csíkszentkirályi fiú életét vesztette, két másik fiatal kórházba került, miután felborultak egy buggy típusú járművel. A sofőr jogosítvány nélkül és ittasan vezetett.
Munkagépek jelentek meg a csíkszeredai Suta-tónál, amelynek gátjánál már dolgoznak. A helyreállítással nemrég megbízott kivitelező átvette a terepet, és mint ígérte, megfelelő felszereltséggel és alkalmazotti létszámmal végzi a feladatot.
Egyelőre nem lehet a 24Pay alkalmazással buszjegyet, parkolójegyet vagy parkolóbérletet vásárolni a Csíki Trans rendszerében.
Noha része a városfejlesztési stratégiának, és évekkel ezelőtt egy helyszín is felmerült, Csíkszeredában egyelőre nincs szükség olyan parkolókra, ahol a városba érkezők autóikat leparkolják, és tömegközlekedéssel utaznak tovább.
Dolgoznak a csíksomlyói kegytemplom külső felújításán: ipari alpinisták restaurálják a tornyokat, közben a főhomlokzat falazatának helyreállítása is zajlik. Az idei pünkösdi búcsúra érkező zarándokokat így állványozott templomhomlokzat fogadja majd.
Emlékestet szerveznek Márton Áron püspök tiszteletére, a közös megemlékezést május 16-án tartják a Szabadság téren Csíkszeredában.
Huszonharmadik alkalommal szervezik meg a Kari Tudományos Diákköri Konferenciát a Sapientia EMTE Csíkszeredai Karán május 13-án.
Úttestre dőlt fa nehezíti a közlekedést a csíkszeredai Zsögödi Nagy Imre utcában kedden délután. A tűzoltók dolgoznak az útakadály eltakarításán.
Székely János szombathelyi megyés püspök lesz a csíksomlyói pünkösdi búcsú szónoka. A szervezés már javában zajlik, az idei búcsú jelmondata pedig a keresztséget állítja középpontba.
Továbbra is bizonytalan, hogy lesz-e lehetőség a csíkszeredai kerékpárutak tervezett bővítésére és felújítására. Az Országos Helyreállítási Tervet (PNRR) érintő megszorítások miatt nem lehet tudni, várható-e finanszírozás más forrásból, vagy nem.
szóljon hozzá!